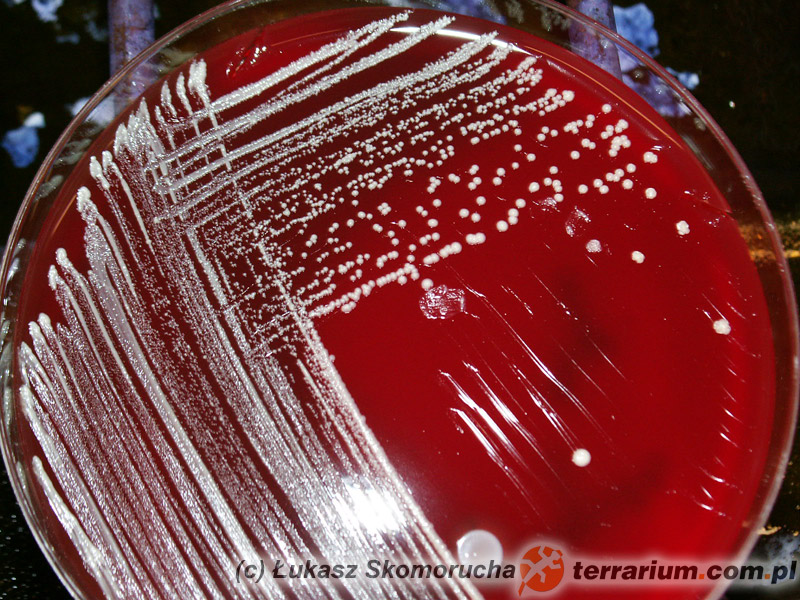

Małpy jako źródło chorób dla ludzi
Małpy zaczynają cieszyć się w ostatnim czasie wzrastającym zainteresowaniem jako potencjalne zwierzęta domowe. Niestety, małpy, nawet z pozoru urocze pazurkowce, raczej nie nadają się na domowych pupili. Odchowanie zwierzęcia tak, by stało się „towarzyszem” człowieka, jest niezwykle trudne i wymaga ogromnej wiedzy i zaangażowania. Najczęściej „przyjaciel”, wraz z wiekiem i osiągnięciem dojrzałości płciowej, staje się bardzo agresywny i za wszelką cenę usiłuje zdominować innych domowników. Jeśli ktoś chce odpowiedzialnie hodować małpy, powinien zbudować dla nich przestronną wolierę i utrzymywać je w warunkach zbliżonych do naturalnych, włączając w to socjalny charakter tych zwierząt, to znaczy utrzymywać je w stadzie ich własnego gatunku, do którego człowiek będzie jedynie „dodatkiem” dostarczającym pokarm. Ubieranie małpek w ubranka autorzy uważają za nieetyczne i zdecydowanie odradzają tego typu praktyki. Podobnie jest z usuwaniem kłów, zabiegiem sugerowanym czasami jako metoda na dotkliwe ugryzienia małp. Zabieg ten, o ile nie ma uzasadnień medycznych, jest niczym innym, jak okaleczaniem zwierzęcia.
Decydując się na zakup małpy, koniecznie należy wziąć pod uwagę możliwość przenoszenia chorób, zarówno z małpy na człowieka, jak również z człowieka na małpy. W pierwszym przypadku mówimy o zoonozach (chorobach odzwierzęcych), w drugim – o zooantroponozach. Sztandarowym przykładem z tej drugiej grupy może być ludzki herpeswirus Herpes simplex, wywołujący u ludzi opryszczkę, potocznie zwaną „zimnem”, będący śmiertelnym zagrożeniem dla pazurkowców. Małpy, z racji znacznego podobieństwa genetycznego i fizjologicznego do ludzi, bywają traktowane jako eksperymentalne modele w badaniach przebiegu licznych chorób ludzkich, stąd stosunkowo dobrze opisanych jest u nich wiele chorób, którymi w warunkach naturalnych zwierzęta nie mogłyby się zarazić.
Istotną rzeczą jest fakt, iż naczelne nie są grupą w pełni jednorodną. Dla potrzeb niniejszego artykułu autorzy zastosowali uproszczony podział na tzw. małpy Starego i Nowego Świata. Małpy Nowego Świata, zamieszkujące Amerykę Środkową i Południową, są obecnie najbardziej popularnymi naczelnymi w Polsce. Małpy Starego Świata, osiągające większe rozmiary, w większości objęte zostały załącznikiem I rozporządzenia o zwierzętach niebezpiecznych i ich posiadanie przez prywatne osoby jest w Polsce zabronione.
Najczęstszymi problemami zdrowotnymi utrzymywanych w niewoli małp są choroby wynikające z błędów chowu i diety. Niedobory żywieniowe, otyłość, MBD to tylko kilka przykładów rezultatów nieodpowiedniej opieki nad małpami. Z drugiej strony zwierzęta te są bardzo podatne na wiele chorób wirusowych i bakteryjnych. Najważniejsze z nich pod kątem zagrożeń dla człowieka omówimy w niniejszym artykule.
Wspomniany już występujący u ludzi Herpes simplex powoduje u marmozet i tamaryn śmiertelną chorobę o bardzo ostrym przebiegu, powodującą owrzodzenia w obrębie jamy ustnej i na języku oraz ogniskowe zmiany martwicze i krwotoczne w różnych narządach, głównie w mózgu, wątrobie, śledzionie, sercu, płucach i nerkach. Często choroba przebiega tak gwałtownie, że zanim zaobserwuje się jej objawy, zwierzę umiera. Czasami stwierdza się apatię, znaczne ograniczenie apetytu, silny ślinotok wynikający z owrzodzeń w jamie ustnej. Równie wrażliwe na zakażenie HHV są lemury. Osoby z aktywną fazą choroby, tj. z widocznymi objawami zakażenia, powinny kategorycznie unikać kontaktu z pazurkowcami. Leczenie podejmowane w przypadku zakażenia wirusem Herpes simplex jest niemal zawsze nieskuteczne.
Bardzo istotny jest wirus herpes B występujący stosunkowo powszechnie u azjatyckich makaków (Macaca spp.). Wirus wywołuje u nich zmiany podobne do ludzkiej opryszczki, jest jednak bardzo niebezpieczny dla innych małp. Spośród 26 w pełni potwierdzonych i dokładnie opisanych przypadków zachorowań u ludzi, 16 zakończyło się śmiercią w objawach zapalenia mózgu. Ostatni opisany przypadek u ludzi pochodzi z 2008 roku. Zakażenia u innych naczelnych w większości przypadków kończyły się śmiercią. Opisano jednak przypadek obecności wirusa u kapucynek (Cebus apella), które nie wykazywały żadnych objawów chorobowych. U dzikich małp wirus jest bardzo szeroko rozpowszechniony – stwierdzano go nawet u 100% osobników w niektórych populacjach. Zarażenie człowieka następuje poprzez kontakt z zainfekowaną śliną lub krwią, poprzez pogryzienia lub zadrapania, ale również poprzez kontakt z materiałem laboratoryjnym. Pierwsze objawy u ludzi pojawiają się w przeciągu miesiąca od zakażenia i przypominają początki grypy. Szybko jednak pojawiają się różnego typu objawy nerwowe, a choroba kończy się martwicowym zapaleniem mózgu i rdzenia kręgowego. Do niedawna śmiertelność u ludzi oceniana była na ponad 70%. Rozporządzenie ministra środowiska z 3 sierpnia 2011 r. w sprawie gatunków zwierząt niebezpiecznych dla życia i zdrowia ludzi (Dz.U.Nr 173,poz.1031) zalicza wszystkie makaki do kategorii zwierząt najbardziej niebezpiecznych i zakazuje ich posiadania przez osoby prywatne. Sprawia to, że w warunkach polskich ryzyko wystąpienia tej groźnej zoonozy jest na szczęście znikome.
Godną wspomnienia sprawą jest fakt, że istnieje wiele różnych herpeswirusów specyficznych dla poszczególnych gatunków małp. Niemal u 100% dzikich saimiri występuje Herpesvirus saimiri, a u czepiaków Herpesvirus atels. Wirusy te ni są niebezpieczne dla ludzi, jednak u marmozet i tamaryn przyczyniają się do rozwoju nowotworowych zmian – chłoniaków. Dlatego nie jest wskazane łączenie w jednej hodowli tych gatunków.
Odra jest zakaźna praktycznie dla wszystkich naczelnych, chociaż właściwym źródłem wirusa jest człowiek. Wirus bardzo rzadko występuje u dzikich małp i to wyłącznie u tych, które mają stały i bezpośredni kontakt z człowiekiem. Odra może przebiegać bezobjawowo, zwykle jednak powoduje chorobę o ostrym przebiegu i śmiertelności sięgającej 25%. Objawy kliniczne obejmują: zapalenie spojówek, katar, obrzęk powiek, osłabienie i wysypkę. Może pojawić się zapalenie płuc i oskrzeli, a także biegunka. Wirus powoduje też znaczny spadek odporności, co prowadzi do wtórnych chorób grzybiczych i bakteryjnych. Zgon może nastąpić w przeciągu 8-18 godzin. U małp Nowego Świata często nie obserwuje się żadnych objawów, a nagła śmierć następuje w wyniku ostrych zapaleń przewodu pokarmowego lub zapalenia mózgu. W ich przypadku śmiertelność sięga nawet 100%. Brak jest terapii specyficznej.
Duże znaczenie w medycynie mają cztery wirusy określane jako pokswirusy. Należał do nich również wirus ospy prawdziwej, niezwykle groźnej i zaraźliwej choroby ludzi, którą udało się całkowicie wytępić w 1980 r. Nie tak dawno opisano jednak blisko z nim spokrewniony wirus ospy małpiej („monkeypox”), który jednak jest znacznie mniej niebezpieczny. Objawy kliniczne u ludzi i małp są bardzo podobne – choroba zaczyna się od wystąpienia gorączki, po której pojawiają się (głównie na skórze twarzy, dłoni i podeszew stóp) grudki średnicy 1-4 mm. Grudki po kilku dniach przekształcają się w pęcherze, następnie w krosty i strupy, które odpadając pozostawiają po sobie blizny. Często objawy skórne są jedynymi obecnymi, czasem pojawia się także zapalenie płuc i biegunka. U ludzi ważnym objawem jest bardzo często występujące powiększenie węzłów chłonnych, które różnicuje ospę małpią od ospy prawdziwej i wietrznej. Wysypka utrzymuje się 2-6 tygodni. Wbrew swojej nazwie, głównym rezerwuarem Monkeypox virus są nie małpy, a dzikie gryzonie. Wirus pochodzi z centralnej i zachodniej Afryki, gdzie ludzie zarażają się nim głównie poprzez polowania na zakażone małpy (stąd określenie „małpia ospa”). Dwa inne wirusy – Tanapox virus i Yaba monkey tumor virus – również występują w tropikalnych rejonach Afryki i stanowią zagrożenie głównie dla tamtejszej ludności. Przenoszą się z małp na ludzi głównie za pośrednictwem owadów krwiopijnych, jednak w warunkach polskich nie mają żadnego znaczenia.
Małpy, podobnie jak wszystkie ssaki, są wrażliwe na zakażenie wścieklizną. Może rozwijać się ona po kontakcie z zakażonym zwierzęciem, ale również odnotowano przypadki pojawienia się objawów choroby po zastosowaniu niektórych szczepionek przeciw tej chorobie. Wprawdzie przypadki zakażeń ludzi od małp są rzadkie, jednak w samej Brazylii w latach 1991-98 na 13 śmiertelnych przypadków wścieklizny u ludzi 8 spowodowanych było pogryzieniami przez uistiti białouche (Callithrix jacchus), bardzo popularne ostatnimi czasy w Polsce. Dlatego też małpy utrzymywane w wolierach zewnętrznych, szczególnie w rejonach, w których wścieklizna była stwierdzana, mogą stanowić realne zagrożenie dla człowieka.
Wirusy z rodzaju Lentivirus są niezwykle istotne z medycznego punktu widzenia. Należy do nich wirus HIV, który w świetle badań, pochodzi od afrykańskich małp, dokładniej od szympansów (Pan troglodytes) i mangaby szarej (Cercocebus atys). Na drodze skomplikowanych mutacji, których autorzy nie będą opisywać w ramach niniejszego tekstu, doszło do przeniesienia się małpich lentiwirusów, określanych jako SIV, na człowieka, najpewniej poprzez zjadanie mięsa upolowanych małp. Dziś wiadomo, że istnieje około 40 różnych SIV-ów oraz że u naturalnych gospodarzy praktycznie nie wywołują objawów chorobowych. „Przeskoczenie” z małp na ludzi nastąpiło prawdopodobnie na przełomie XIX i XX wieku i to kilkakrotnie, o czym świadczy mnogość opisanych wariantów HIV. Niektóre są bardzo niebezpieczne dla ludzi i wywołały ogólnoświatową pandemię, inne praktycznie nie stanowią zagrożenia i opisane były u jednej – kilku osób, które miały bezpośrednią styczność z danym gatunkiem małpy. Niemniej jednak, trudno jest przewidzieć, który wirus będzie akurat dla człowieka tym niebezpiecznym, a który niegroźnym, dlatego należy uznać każdego osobnika małpy-nosiciela wirusa SIV za potencjalne zagrożenie dla zdrowia ludzi.
Określenie „gorączki krwotoczne” jest bardzo szerokie i obejmuje kilkanaście chorób, z których najbardziej znane są te wywoływane przez wirusy Ebola. Wprawdzie prawdziwym rezerwuarem (gatunkiem, u którego wirus żyje), jest najprawdopodobniej któryś z dużych owocożernych nietoperzy, jednak większość wybuchów epidemii gorączek Ebola i Marburg wiązała się z kontaktem ludzi z małpami. Małpy są równie wrażliwe na zachorowanie jak ludzie i wykazują podobne objawy – bardzo wysoką gorączkę połączoną z dreszczami oraz wybroczyny i wylewy zarówno wewnętrzne, jak i zewnętrzne. Wirus szerzy się przez kontakt z zakażonymi płynami ustrojowymi, a więc chociażby krwią, której przed śmiercią chory organizm traci duże ilości. Zdawać by się mogło, że gorączki krwotoczne to choroby egzotyczne, nie mające szans pojawić się w Europie. Jednak wirus Marburg, bardzo blisko spokrewniony z Ebola i wywołujący bardzo podobne objawy, został opisany po raz pierwszy właśnie w Europie, dokładniej w Niemczech (miasta Marburg i Frankfurt nad Menem) i w ówczesnej Jugosławii (Belgrad obecnie leżący na terenie Serbii) w 1967 roku w wyniku zakażeń personelu pracującego z koczkodanami zielonymi (Chlorocebus aethiops) w ośrodkach produkujących szczepionkę na chorobę Heinego-Medina. W 2005 roku na lotnisku de Gaulle’a w Paryżu udaremniono przemyt młodego szympansa karłowatego (Pan panicus), którego ze względu na zagrożenie wirusem Ebola w trybie pilnym i przy zachowaniu szczególnych środków ostrożności odesłano do kraju pochodzenia.
Małpy często wykorzystywane są jako eksperymentalne modele do badań nad różnymi ludzkimi chorobami. Udowodniono, że zarazić się mogą wirusowym zapaleniem wątroby, w szczególności typu A, które jest bardzo niebezpieczne dla małp Nowego Świata.
Małpy, szczególnie azjatyckie gatunki małp Starego Świata, są bardzo wrażliwe na zakażenie gruźlicą. Nieco bardziej oporne są gatunki afrykańskie. Gatunki amerykańskie wykazują stosunkowo najwyższą oporność na gruźlicę, jednak i u nich dojść może do zakażenia tą groźna chorobą. Spośród małp Nowego Świata zdecydowanie najczęściej stwierdzano gruźlicę u sajmiri. Choroba może przebiegać bezobjawowo, ewentualnie z pojawiającym się od czasu do czasu kaszlem, zawsze jednak kończy się śmiercią, zwykle w przeciągu kilku – kilkunastu miesięcy od zakażenia. Małpa, mimo że nie wykazuje objawów, może aktywnie prątkować, to znaczy uwalniać bakterie do środowiska i zakażać tym samym swoich opiekunów lub inne osobniki w stadzie. Podstawowym testem potwierdzającym lub wykluczającym gruźlice u małp i ludzi jest próba tuberkulinowa, polegająca na wstrzyknięciu śródskórnym tuberkuliny – białka wytwarzanego przez bakterie wywołujące chorobę. W zależności od odczynu, określa się status zdrowia danego osobnika. W przypadku ludzi zwykle test wykonuje się na przedramieniu, u małp, z racji owłosienia i trudności przy odczycie próby, wygodniej jest podać tuberkulinę w powiekę. Testom na gruźlicę powinny być poddawane wszystkie małpy, nawet te pozornie odporne na tę chorobę. Testy wykonuje się także u zwierząt w ogrodach zoologicznych.
Pojawienie się biegunek tła bakteryjnego u domowych naczelnych może wynikać z niewłaściwej higieny przechowywanego pożywienia (np. produktów pochodzenia drobiowego), ale również z zakażeń bakteriami stanowiącymi poważne zagrożenie również dla ludzi. Mowa tu miedzy innymi o salmonellozie, kampylobakteriozie i szigelozie. Wszystkie te choroby mogą przenosić się zarówno z człowieka na małpę, jak i z małpy na człowieka. Szczególnie narażone są dzieci i osoby z obniżoną odpornością.
U uistiti białouchych opisano pneumocystozowe zapalenie płuc wywołane przez grzyb z gatunku Pneumocystis jirovecii. Zwykle występuje on u osobników z osłabioną odpornością. Przenosi się drogą kropelkową. Zwrócić należy szczególna uwagę na fakt, iż ten drożdżopodobny organizm może być bardzo niebezpieczny również dla ludzi z obniżoną odpornością (przyjmujących leki immunosupresyjne, po przeszczepach czy zarażonych wirusem HIV). O ile u w pełni zdrowych osób grzyb ten nie stanowi większego zagrożenia, to u osób z pełnoobjawowym AIDS śmiertelność przy zakażeniu Pneumocystis jirovecii może sięgać nawet ponad 30%.
Grzybice skórne zdarzają się u małp rzadko. Jeśli jednak wystąpią, stanowią takie samo zagrożenie przeniesienia na człowieka, jak w przypadku kotów czy psów.
Toksoplazmoza jest chorobą wywoływaną przez pierwotniaka Toxoplasma gondii. U ludzi jest szczególnie groźna, kiedy przybiera postać tak zwanej toksoplazmozy wrodzonej. Wówczas zakażenie następuje jeszcze w łonie matki, doprowadzając do różnorakich zaburzeń rozwojowych i trwałych upośledzeń. Pazurkowce są również bardzo podatne na toksoplazmozę, która u nich zwykle kończy się śmiercią. Na szczęście, ryzyko zakażenia małpa-człowiek lub człowiek-małpa jest praktycznie równe zeru. Znacznie większe zagrożenie stanowią ostateczni żywiciele pierwotniaka – koty, które przez pewien czas od zarażenia się wydalają pasożyta z kałem. Zakażenie małp może nastąpić także poprzez zjedzenie zakażonej myszy lub innego gryzonia, będącego żywicielem pośrednim dla Toxoplasma.
Inne pierwotniaki mogą wywoływać biegunki. Mowa w tym miejscu o Entamoeba histolytica czy Balantidium coli. Pasożyty te mogą być bardzo groźne dla pazurkowców, gdyż przy silnej inwazji doprowadzić mogą nawet do śmierci (opisano przypadki śmierci nawet u goryli). Jednocześnie podkreślić należy fakt, iż te same pierwotniaki mogą również „zaatakować” ludzi opiekujących się małpami, przy czym – na szczęście – rzadko namnażają się u nich w ilościach, które mogłyby zagrozić naszemu życiu. Niemniej jednak, mogą doprowadzić do uporczywych, długotrwałych biegunek. Zakażenie może odbywać się również w przeciwnym kierunku – to małpy mogą zakazić się od chorego opiekuna. Biegunkę i tak zwany zespół złego wchłaniania wywołuje również Gargia spp., dość licznie występująca u ludzi i innych zwierząt towarzyszących. Tak naprawdę, nie wiadomo, czy pierwotniak ten stanowi poważne zagrożenie dla pazurkowców. Ponadto małpy są wrażliwe na zarażenie ludzkim owsikiem, jednak dotychczas brak jest doniesień o występowaniu tego nicienia u tamaryn i marmozet.
Wreszcie dochodzimy do zagrożenia związanego z pasożytami zewnętrznymi, które de facto u małp utrzymywanych w prywatnych hodowlach zdarzają się rzadko. Jednak w razie wystąpienia inwazji owadów krwiopijnych (pluskwy, wszy, pchły) mogą się one przenieść z małp na ludzi. Z jednej strony ich ukąszenia są nieprzyjemne i mogą wywołać reakcje alergiczne, z drugiej – mogą przenosić z małp na ludzi różnorakie wirusy i bakterie, znajdujące się we krwi.
Opracowanie i źródła informacji
Opracowali lek.wet. Marta Marciniak i lek.wet. Łukasz Skomorucha na podstawie własnych doświadczeń klinicznych oraz literatury:
- Meredith A. Redrobe S. „BSAVA Manual of Exotic Pets, 4th Edition”
- Renquist D., Whitney R. „Zoonoses Acquired from Pet Primates”
- Voevodin A., Marx P. „Simian Virology”
lek.wet. Marta Marciniak
marta.kamila.marciniak@gmail.com
lek.wet. Łukasz Skomorucha
lukasz_skomorucha@wp.pl
Przychodnia Weterynaryjna SALVET
ul.Ratuszowa 1/3
Warszawa
22 670 20 42
Przychodnia Weterynaryjna OSTOJA SALVET
ul. Hlonda 2 lok.7
22 651 89 79
www.salvet.pl
Liczba wyświetleń: 16523



(13 votes, average: 4,08 out of 5)